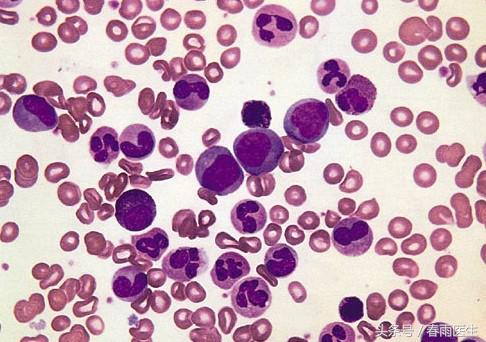
我不是药神最终挣多少钱,我不是药神30000块钱的药吃了三年

7月,春雨君最期待的电影是《我不是药神》。影片根据真实故事改编,徐峥饰演的角色从保健品商一跃成为印度仿制药“格列宁”的独家代理商,个人经济能力大幅提升的同时,也成为慢性粒细胞白血病患者的救命稻草。
如果你也对即将上映的《我不是药神》感兴趣,那可要看下春雨君今天科普的内容,能让你更好的理解这部电影的内容和温度。
慢性粒细胞白血病是什么?
粒细胞是一种白细胞,正常状态下,它由骨髓中的造血干细胞分化而成的。
大多数慢性粒细胞白血病是由于基因问题导致的,患者体内名为“费城”的染色体发生染色体易位现象,产生一种新的融合基因。
这一变化会导致体内骨髓中的不成熟粒细胞肆意生长,疯狂扩张,影响血液和骨髓,数量极大的粒细胞会挤压正常血细胞的生存空间、抑制骨髓的正常造血。
|慢性粒细胞白血病慢性期外周血涂片|
患者会有哪些表现?
1. 悄无声息地起病
患者早期症状非常隐匿,且都为非特异性症状(如疲劳、虚弱、食欲减退、体重减轻、发热、盗汗或腹部饱胀感),这些症状会持续数月到数年。
部分患者可能会疏忽,另一部分灵敏的患者可能会因为这些非特异性症状就诊。
2. 疾病加速期
进入到第二阶段,不正常工作的细胞增多,患者会出现明显的症状,如下:
- 感觉很累
- 发烧
- 容易淤伤
- 盗汗
- 呼吸急促
- 体重丢失
- 身体左侧肿胀或疼痛,这一般是脾脏肿大的信号
- 面色苍白
- 感觉到骨头疼痛
3. 急变期
粒细胞开始大量繁殖并排挤健康的血细胞和血小板,患者会出现与急性白血病相似的症状:
- 感染
- 出血
- 皮肤出现肿块和肿瘤
- 腺体肿胀
- 骨头痛
- 败血症

药物治疗可以延长生存期
除了造血干细胞移植可以成功治愈该病外,其他治疗方法不能治愈本病,但是找到能配型成功干细胞捐赠者是不容易的。
在幸运降临前,大多数患者可以使用药物治疗或者药疗结合化疗的方法来延长生存期。
基本原则是减少疯狂增殖的“坏细胞”,并将健康的血细胞恢复到正常水平。
使用药物酪氨酸酶*制剂抑**可以达成这个效果,它能减慢体内“坏细胞”的生长速度,延长生存期。
临床上会使用的药物有:
- 博舒替尼
- 达沙替尼
- 伊马替尼(格列卫,即为电影化名“格列宁”的药物)
- 尼洛替尼

1年30万,这个命还续不续
慢性粒细胞白血病患者服用格列宁确实可以稳定病情、正常生活,但需不间断服用。
2002年,该电影的原型人物陆勇接受采访时表示,这种药品的售价是 23500 元一盒,一名慢粒白血病患者每个月需要服用一盒,药费加治疗费用几乎掏空了他的家底,这样算下来一年需要花费30万元。这样的花销是普通家庭不能承受的。
而印度的仿制药,可以理解为“盗版药”价格仅为200元每盒,是正版药的百分之一,一年的花销也降到了3万左右,对于大多数患者来讲,是件救命的事儿。

可是,仿制药表面上解决了“吃不起药,想活下去”的问题,却带来了更大的问题。
每一种新药的研发都需要投入巨大的人力物力财力,短则几年,长则几十年。
如果“盗版药”猖獗,那么又有哪个药企愿意投入资金在新药的研发上呢?疗效更好、副作用更低的药品由谁来创造呢?
这个问题市场解决不了,政策能解决吗?
医疗狗春雨君准备带着这些问题去看下《我不是药神》,欢迎有想法的小伙伴和春雨君讨论。
参考资料:
1. WebMD. Chronic Myelogenous Leukemia (CML)
2. 默沙东诊疗手册. 慢性粒细胞性白血病 (CML)
3. 北京青年报. 抗癌药代购第一人:获释后每天上百名患者找我
文:大王
题图来源:《我不是药神》
版权声明:本文为春雨医生原创稿件,版权归属春雨医生所有,未经授权禁止转载,授权与合作事宜请联系reading@chunyu.me